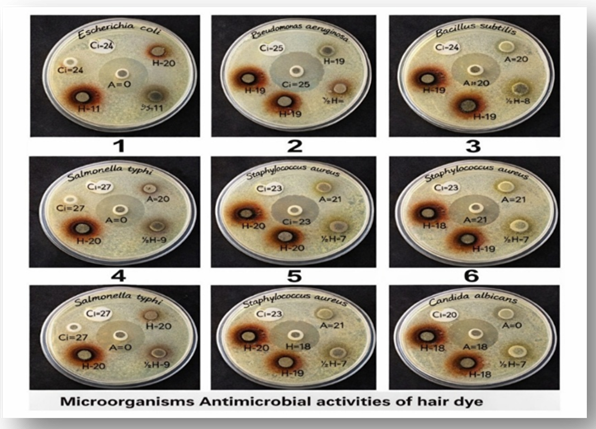

We use cookies to ensure our website works properly and to personalise your experience. Cookies policy

We use cookies to ensure our website works properly and to personalise your experience. Cookies policy
NRI College of Pharmacy, Pothavrappadu, Agiripalli, Eluru, 521212.
The increasing use of synthetic hair dyes containing ammonia, hydrogen peroxide, and para-phenylenediamine has raised serious health concerns, including scalp irritation, allergic reactions, and hair damage. This has led to growing interest in herbal alternatives that are safer and environmentally friendly. The present study focuses on the formulation and evaluation of a polyherbal hair dye using Phyllanthus reticulatus fruit as the primary natural colouring agent. The fruit extract, rich in tannins, flavonoids, and phenolic compounds, was combined with other herbal ingredients such as Hibiscus rosa-sinensis, Lawsonia inermis, and Emblica officinalis to enhance colouring efficiency and conditioning properties. The formulated dye was evaluated for organoleptic characteristics, physicochemical parameters, pH, spreadability, stability, washability, and safety through patch testing. The results showed satisfactory colour deposition, good stability, and compatibility with scalp pH without causing irritation. Additionally, the formulation exhibited antioxidant and antimicrobial properties beneficial for scalp health. The study concludes that the developed polyherbal hair dye is a safe, effective, eco-friendly, and economical alternative to synthetic hair dyes with added therapeutic benefits.
Herbal hair dye is a natural cosmetic preparation used to colour the hair using plant-based ingredients. It contains botanical extracts that help in colouring, nourishing, and protecting the hair. Unlike synthetic hair dyes that contain harmful chemicals such as ammonia, hydrogen peroxide, and para-phenylenediamine, herbal hair dyes use natural ingredients and are safer for regular use. Herbal hair dyes not only provide colour but also improve hair health, strengthen hair, and protect the scalp. These herbal preparations are rich in natural colouring agents such as tannins, flavonoids, and phenolic compounds, which help in colouring the hair naturally without damaging its structure.
One such important plant used in herbal hair dye is Phyllanthus reticulatus, which belongs to the family Phyllanthaceae. The fruits of this plant contain natural colouring pigments that help in colouring the hair. The plant also possesses antioxidant, antimicrobial, and medicinal properties which help in maintaining healthy hair and scalp.
Polyherbal hair dye is a preparation containing more than one herbal ingredient to improve effectiveness. Common herbal ingredients used include henna, hibiscus, and amla, which help in better colouring, conditioning, and strengthening the hair.[1]
Natural ingredients: Common ingredients include phyllanthus rectus , hibiscus, Lawsonia inermis, Eclipta Prostrata, Emblica officinalis, Vitex Negundo, Surma Stone (Tutty / Tutia).
Hair and Scalp Benefits:
Many herbal ingredients have:
These properties help maintain healthy hair and scalp.
Colouring and Conditioning Property:
Herbal hair dyes help to:
Safe and Eco-friendly:
Herbal hair dyes are:
Functions of Herbal Hair Dye:
Advantages of Herbal Hair Dye:
Disadvantages of Synthetic Hair Dye:
Characteristics of Herbal Hair Dye
An ideal herbal hair dye should possess good colouring ability and provide uniform colour to the hair without causing any damage. It should be safe, non-toxic, and free from harmful chemicals so that it does not cause scalp irritation, allergy, or hair fall. The hair dye should have good stability and should remain effective during storage. It should be easy to apply and spread uniformly on the hair. The formulation should have suitable consistency and should not be too thick or too thin. It should also have good washability and should retain colour on the hair for a longer period. In addition to colouring, the herbal hair dye should provide conditioning effect, improve hair texture, increase shine, and maintain scalp health. It should be economical, eco-friendly, and acceptable in terms of colour, odour, and appearance.[3]
PLANT PROFILE:
1. Phyllanthus reticulatus

Figure1 : Image of Phyllanthus reticulatus
Scientific name: Phyllanthus reticulatus
Family: Phyllanthaceae
Synonyms:
Chemical constituents:
Uses:
2. Hibiscus

Figure2 : Image of Hibiscus
Scientific name: Hibiscus rosa-sinensis
Family: Malvaceae
Synonyms:
Chemical constituents:
Uses:
3. Lawsonia inermis

Figure 3: Lawsonia inermis
Scientific name: Lawsonia inermis
Family: Lythraceae
Synonyms:
Chemical constituents:
Uses:
4. Eclipta prostrata

Figure 4: Image of Eclipta prostrata
Scientific name: Eclipta prostrata
Family: Asteraceae
Synonyms:
Chemical constituents:
Uses:
5. Emblica officinalis

Figure 5: Image of Embelica officinalis
Scientific name: Emblica officinalis
Family: Phyllanthaceae
Synonyms:
Chemical constituents:
Uses:
6. Vitex negundo

Figure 6 : Image of Vitex negundo
Scientific name: Vitex negundo
Family: Verbenaceae
Synonyms:
Chemical constituents:
Uses:
7. Surma Stone (Tutty / Tutia)

Figure 7: Image of Surma stone
Scientific name: Zinc oxide (mineral origin)
Synonyms:
Chemical constituents:
Zinc oxide
Uses:
EXCIPIENT PROFILE :
1. Ethanol
Type: Solvent
Role: Used as extraction solvent and helps dissolve active constituents.
Description: Ethanol is a clear, colourless, volatile liquid with characteristic odour. It is widely used in pharmaceutical and cosmetic formulations.[6]
IUPAC Name: Ethanol
Chemical Formula: C?H?O
Chemical Structure:

Figure 8: Structure of ethanol
2. Propylene Glycol
Type: Humectant and Solvent
Role: Helps retain moisture and improves penetration of ingredients.
Description: It is a clear, colourless, viscous liquid used in cosmetic preparations.
IUPAC Name: Propane-1,2-diol
Chemical Formula: C?H?O?
Chemical Structure:

Figure 9: Structure of propylene glycol
3. PVP K30
Type: Binder and Film-forming agent
Role: Helps in binding and improves stability of formulation.
Description: It is a white hygroscopic powder soluble in water and alcohol.[7]
IUPAC Name: Poly(1-vinylpyrrolidin-2-one)
Chemical Formula: (C?H?NO)n
Chemical Structure:

Figure 10: Structure of PVP K 30
4. Glycerin
Type: Humectant
Role: Provides moisture and softness to hair.
Description: It is a clear, colourless, viscous liquid with sweet taste.[8]
IUPAC Name: Propane-1,2,3-triol
Chemical Formula: C?H?O?
Chemical Structure:

Figure 11: Structure of Glycerin
5. Xanthan Gum
Type: Thickening agent
Role: Provides viscosity and stability to formulation.
Description: It is a cream coloured powder soluble in water.[9]
IUPAC Name: Polysaccharide (Xanthan)
Chemical Formula: (C??H??O??)n
Chemical Structure:

Figure 12: Structure of Xanthum gum
6. Phenoxy Ethanol
Type: Preservative
Role: Prevents microbial growth.
Description: It is a colourless oily liquid used as preservative.[10]
IUPAC Name: 2-Phenoxyethanol
Chemical Formula: C?H??O?
Chemical Structure:

Figure 13: Structure of Phenoxy ethanol
MATERIALS AND METHODS:
Table 1: Formulation Table
|
Sr. No |
Ingredients |
Quantity |
Role |
|
1 |
Phyllanthus reticulatus |
50 g |
Main colouring agent |
|
2 |
Hibiscus rosa-sinensis |
10 g |
Pigment intensifier and conditioner |
|
3 |
Lawsonia inermis |
10 g |
Natural dye pigment |
|
4 |
Eclipta prostrata |
10 g |
Dark colour enhancer |
|
5 |
Emblica officinalis |
10 g |
Hair conditioner |
|
6 |
Vitex negundo |
10 g |
Scalp conditioning agent |
|
7 |
Surma stone (Tutty) |
1 g |
Colour enhancer |
Table 2: Solvent System
|
Sr. No |
Solvent |
Quantity |
Role |
|
1 |
Ethanol |
600 ml |
Extraction solvent |
|
2 |
Distilled water |
300 ml |
Polar solvent |
|
3 |
Propylene glycol |
100 ml |
Humectant and dye fixation |
Table 3: Cosmetic Base
|
Sr. No |
Ingredient |
Quantity |
Role |
|
1 |
PVP K30 |
1.5 g |
Binding agent |
|
2 |
Aloe vera gel |
50 ml |
Conditioner |
|
3 |
Glycerin |
30 ml |
Moisturizer |
|
4 |
Xanthan gum |
3 g |
Thickening agent |
|
5 |
Phenoxyethanol |
5 ml |
Preservative |
|
6 |
Citric acid |
Q.S |
pH adjustment |
METHOD OF PREPARATION
Step 1: Collection and Drying
Step 2: Extraction
Step 3: Preparation of Herbal Powder
Step 4: Preparation of Base
Step 5: Preparation of Hair Dye
Step 6: Storage
EVALUATION OF HERBAL HAIR DYE
The prepared herbal hair dye was evaluated by the following tests:
1. Organoleptic Evaluation
Purpose: To evaluate physical appearance using sensory organs.
Parameters evaluated:
Procedure:
The prepared dye was visually observed for colour and appearance. The odour was checked by smelling. Texture and consistency were checked by touching and rubbing between fingers.
2. pH Determination
Purpose: To determine scalp compatibility.
Procedure:
3. Moisture Content
Purpose: To determine stability and storage quality.
Procedure:
Result:
Low moisture content indicates good stability.
4. Ash Value
Purpose: To determine purity.
Procedure:
5. Phytochemical Evaluation
Purpose: To detect active constituents.
Tests performed:
6. Rheological Evaluation
Purpose: To determine flow properties.
Parameters:
7. Patch Test
Purpose: To check skin irritation.
Procedure:
8. Stability Study
Purpose: To determine formulation stability.
Procedure:
Stored at:
Result:
Formulation was stable.
9. Antimicrobial Test
Purpose: To check antimicrobial activity.
Procedure:
Disc diffusion method was used.
Figure 14: Antimicrobial testing of hair dye
Table 4 : Physico chemical tests of hair dye
|
Sr. No |
Test |
Observation |
Result |
|
1 |
Colour |
Brownish black |
Acceptable |
|
2 |
Odour |
Pleasant |
Acceptable |
|
3 |
Appearance |
Smooth and uniform |
Good |
|
4 |
Texture |
Smooth |
Good |
|
5 |
Consistency |
Semi-solid paste |
Suitable |
|
6 |
pH |
6.2 |
Suitable for scalp |
|
7 |
Moisture Content |
4.5% |
Within limit |
|
8 |
Ash Value |
6.8% |
Acceptable |
|
9 |
Bulk Density |
0.52 g/ml |
Good |
|
10 |
Tapped Density |
0.63 g/ml |
Good |
|
11 |
Angle of Repose |
27.5° |
Excellent flow |
|
12 |
Phytochemical Test |
Flavonoids, Tannins present |
Active compounds present |
|
13 |
Patch Test |
No irritation |
Safe |
|
14 |
Stability Study |
No change in colour, odour |
Stable |
|
15 |
Antimicrobial Test |
Zone of inhibition observed |
Effective |
RESULTS AND DISCUSSION
The polyherbal hair dye formulated using Phyllanthus reticulatus fruit and other herbal ingredients was evaluated for various parameters. The organoleptic evaluation showed that the formulation had a brownish-black colour, pleasant odour, smooth texture, and uniform appearance, which indicates good acceptability. The pH of the formulation was found to be 6.2, which is within the normal range of scalp pH, indicating that it is safe for application and does not cause irritation.
The moisture content and ash value were within acceptable limits, showing good quality and purity of the formulation. The phytochemical tests confirmed the presence of flavonoids, tannins, and phenolic compounds, which are responsible for colouring and antioxidant activity. The rheological properties such as bulk density, tapped density, and angle of repose indicated good flow properties.
The patch test showed no redness, irritation, or allergic reaction, which confirms the safety of the formulation. The stability study revealed that there was no significant change in colour, odour, or appearance during storage, indicating good stability. The colouring ability test showed that the formulation imparted a uniform brownish-black colour and improved hair texture.
Overall, the results confirmed that the prepared polyherbal hair dye is safe, stable, and effective for colouring hair naturally.
CONCLUSION
The present study successfully focused on the formulation and evaluation of a polyherbal hair dye using Phyllanthus reticulatus fruit along with other natural ingredients such as Lawsonia inermis, Hibiscus rosa-sinensis, Eclipta prostrata, Emblica officinalis, Vitex negundo, and Surma stone. These ingredients were selected based on their traditional use, natural colouring ability, and beneficial effects on hair health.
The prepared formulation showed satisfactory organoleptic properties including good colour, pleasant odour, smooth texture, and uniform appearance, indicating good product acceptability. The physico-chemical parameters such as pH, moisture content, and ash value were found to be within acceptable limits, confirming the stability and purity of the formulation. Phytochemical screening confirmed the presence of active constituents like tannins, flavonoids, and phenolic compounds responsible for colouring and antioxidant activity.
The rheological evaluation indicated good flow properties, which ensures ease of handling and application. The patch test confirmed that the formulation is safe and non-irritant to the skin. Stability studies showed no significant changes in physical properties, indicating good stability during storage.
Thus, it can be concluded that the formulated polyherbal hair dye is safe, stable, and effective for natural hair colouring and can be used as a suitable alternative to synthetic hair dyes, which are associated with harmful side effects. The formulation also provides additional benefits such as hair nourishment, strengthening, and protection. Further studies can be carried out to evaluate long-term stability and colouring efficiency on a larger scale.
REFERENCES







R. Tejaswaroop, M. Praveen Krishna, R. Rohith, U. Sai Charan, U. Ratna Rao, P. Gayatri Devi, Dr. Y. Ankamma Chowdary, Formulation and Evaluation of a Polyherbal Hair Dye using Phyllanthus reticulatus Fruit, Int. J. of Pharm. Sci., 2026, Vol 4, Issue 3, 751-762. https://doi.org/10.5281/zenodo.18918426
 10.5281/zenodo.18918426
10.5281/zenodo.18918426